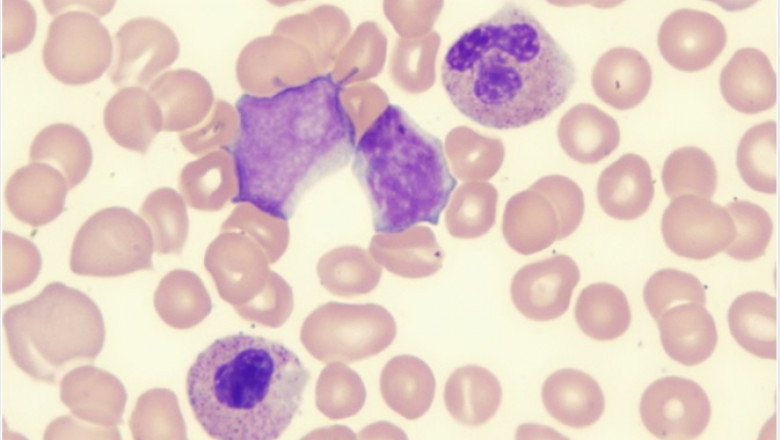

views
The first class Myelodysplastic Syndromes Market document has been generated by keeping in mind all the needs of the businesses for thriving successful business growth. Moreover, market status at the global and regional level is provided through this report which helps to achieve business insights at the extensive marketplace. This information holds an immense significance to drive a business towards the success. Businesses are greatly depending on the different segments involved in the market research report as it offers better insights to drive the business on the right track. Hence the outcome, i.e. an international Myelodysplastic Syndromes Market report, is a great which implies a client-focused, leading edge, and trustworthy market report.
The market data analyzed and evaluated in the credible Myelodysplastic Syndromes Market report makes achieve the business goals and objectives in preset time frame. This global market analysis report encompasses all the company profiles of the major players and brands. Besides, the report offers a thorough synopsis on the study, analysis and estimation of the market and how it is impacting the industry. To prepare this report, detailed market analysis is conducted with the inputs from industry experts. Thus, the credible Myelodysplastic Syndromes Market research report performs an assessment of the growth rate and the market value based on market dynamics and growth inducing factors.
DOWNLOAD FREE SAMPLE REPORT: https://www.databridgemarketresearch.com/request-a-sample/?dbmr=global-myelodysplastic-syndromes-market
The report studies the growth outlook of the global market scenario, including production, consumption, history, and forecast. This research helps to learn the consumption pattern and impact of each end-user on market growth. The report investigates the recent R&D projects performed by each market player. After Reading The Market Report, Readers Can Understand the drivers, restraints, opportunities, and trends affecting the growth of the Myelodysplastic Syndromes Market. The report contains an analysis of key regions holding a significant share of the total market revenue.
Market Analysis and Insights: Myelodysplastic Syndromes Market
Global myelodysplastic syndromes (MDS) market is expected to gain market growth in the forecast period of 2020 to 2027. Data Bridge Market Research analyses the market is growing at a healthy CAGR in the above-mentioned research forecast period. Emerging markets and huge investment in research and development are the factors responsible for the growth of this market.
Major market manufacturers enlisted in this report are:
Otsuka Holdings Co., Ltd., Lupin, Takeda Pharmaceutical Company Limited, Onconova Therapeutics, Helsinn Healthcare SA, Boehringer Ingelheim International GmbH, Johnson & Johnson Services, Inc
Access Full TOC, Table and Figures: https://www.databridgemarketresearch.com/toc/?dbmr=global-myelodysplastic-syndromes-market
The Myelodysplastic Syndromes Market is segmented on the basis of product, wound type and end user. The growth amongst these segments will help you analyze meager growth segments in the industries, and provide the users with valuable market overview and market insights to help them in making strategic decisions for identification of core market applications.
Ascend in the openness to specific poison or change in climate might expand the Myelodysplastic Syndromes Market will inspire the market development, additionally expansion in the mindfulness about treatment and mechanical progression and fast reception of fresher definitions and novel measurements structures are a portion of the significant elements among others driving the Myelodysplastic Syndromes Market. In addition, ascend in the innovative work exercises on the lookout and ascend in the interest from arising economies will additionally set out new open doors for the Myelodysplastic Syndromes Market in the conjecture time of 2021-2028.
ACCESS FULL REPORT: https://www.databridgemarketresearch.com/reports/global-myelodysplastic-syndromes-market
In any case, lacking information about Myelodysplastic Syndromes Market in some agricultural nations and patent expiry from many organizations and presentation of nonexclusive medications of marked variant are the main considerations among others going about as restrictions, and will additionally challenge the Myelodysplastic Syndromes Market in the conjecture time frame referenced previously.
Features Points of the Report:
- The most recent data on how the market is advancing to detail their deals and promoting systems. This Myelodysplastic Syndromes Market report has been made to furnish its peruses with modern data and investigation to uncover arising openings for development.
- The market report covers the key difficulties, serious scene, and segment investigation that can assist organizations with getting understanding into the country-explicit varieties.
- The experts likewise accentuate on the critical patterns and the future chances that can be investigated in the locale than can help organizations in income development.
- To acquire serious knowledge about driving organizations with data about their piece of the pie and development rates.